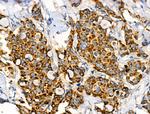
Folate Receptor alpha Antibody in Immunohistochemistry (Paraffin) (IHC (P))
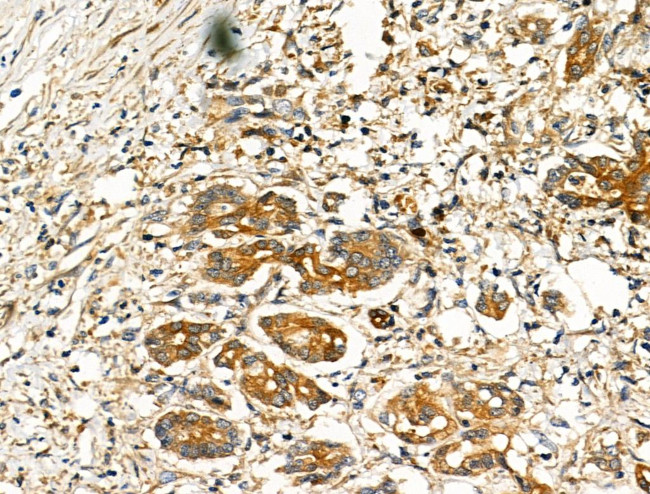
Folate Receptor alpha Antibody in Immunohistochemistry (Paraffin) (IHC (P))

Search
Invitrogen
Folate Receptor alpha Polyclonal Antibody
{{$productOrderCtrl.translations['antibody.pdp.commerceCard.promotion.promotions']}}
{{$productOrderCtrl.translations['antibody.pdp.commerceCard.promotion.viewpromo']}}
{{$productOrderCtrl.translations['antibody.pdp.commerceCard.promotion.promocode']}}: {{promo.promoCode}} {{promo.promoTitle}} {{promo.promoDescription}}. {{$productOrderCtrl.translations['antibody.pdp.commerceCard.promotion.learnmore']}}
FIGURE: 1 / 6
Folate Receptor alpha Antibody (PA5-101588) in IHC (P)

Please note: We are reviewing Western blot images included in the antibody testing data in our catalog, including those provided by third parties. Unless expressly labeled or annotated as “raw-unedited”, Western blot images included in the antibody testing data in our catalog may have been edited, optimized or otherwise adjusted for presentation.
Product Details
PA5-101588
Species Reactivity
Published species
Host/Isotype
Class
Type
Immunogen
Conjugate
Form
Concentration
Amount
Purification
Storage buffer
Contains
Storage conditions
Shipping conditions
RRID
Product Specific Information
Antibody detects endogenous levels of total FOLR1.
Target Information
The protein encoded by this gene is a member of the folate receptor family. Members of this gene family bind folic acid and its reduced derivatives, and transport 5-methyltetrahydrofolate into cells. This gene product is a secreted protein that either anchors to membranes via a glycosyl-phosphatidylinositol linkage or exists in a soluble form. Mutations in this gene have been associated with neurodegeneration due to cerebral folate transport deficiency. Due to the presence of two promoters, multiple transcription start sites, and alternative splicing, multiple transcript variants encoding the same protein have been found for this gene.
For Research Use Only. Not for use in diagnostic procedures. Not for resale without express authorization.
Bioinformatics
Protein Aliases: Adult folate-binding protein; FBP; folate binding protein; folate binding protein 1; Folate receptor 1; folate receptor 1 (adult); Folate receptor alpha; Folate receptor, adult; Folate-binding protein 1; folate-binding protein precursor; FOLR1; FR-alpha; KB cells FBP; MOv18; Ovarian tumor-associated antigen MOv18
Gene Aliases: FBP; FBP1; Folbp-1; Folbp1; FOLR; FOLR1; FR-alpha; FRalpha; NCFTD
UniProt ID: (Mouse) P35846
Entrez Gene ID: (Human) 2348, (Rat) 171049, (Mouse) 14275

Performance Guarantee
If an Invitrogen™ antibody doesn't perform as described on our website or datasheet,we'll replace the product at no cost to you, or provide you with a credit for a future purchase.*
Learn more
We're here to help
Get expert recommendations for common problems or connect directly with an on staff expert for technical assistance related to applications, equipment and general product use.
Contact tech support